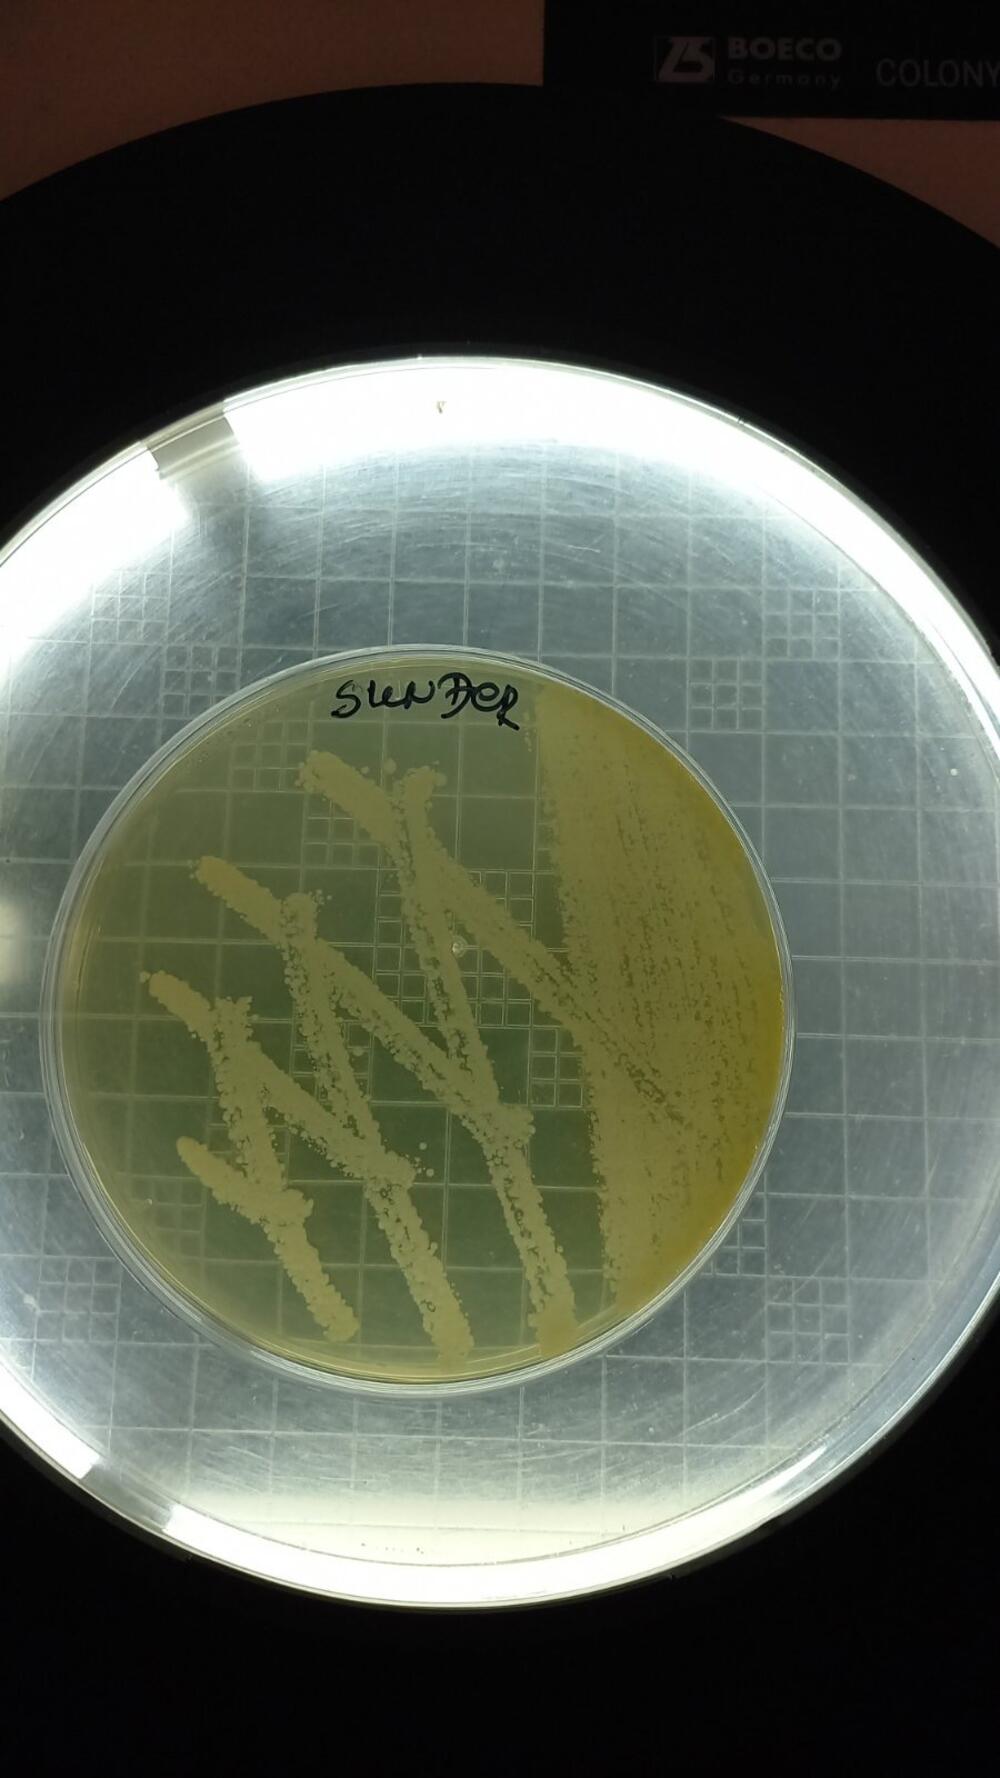
Sunđer
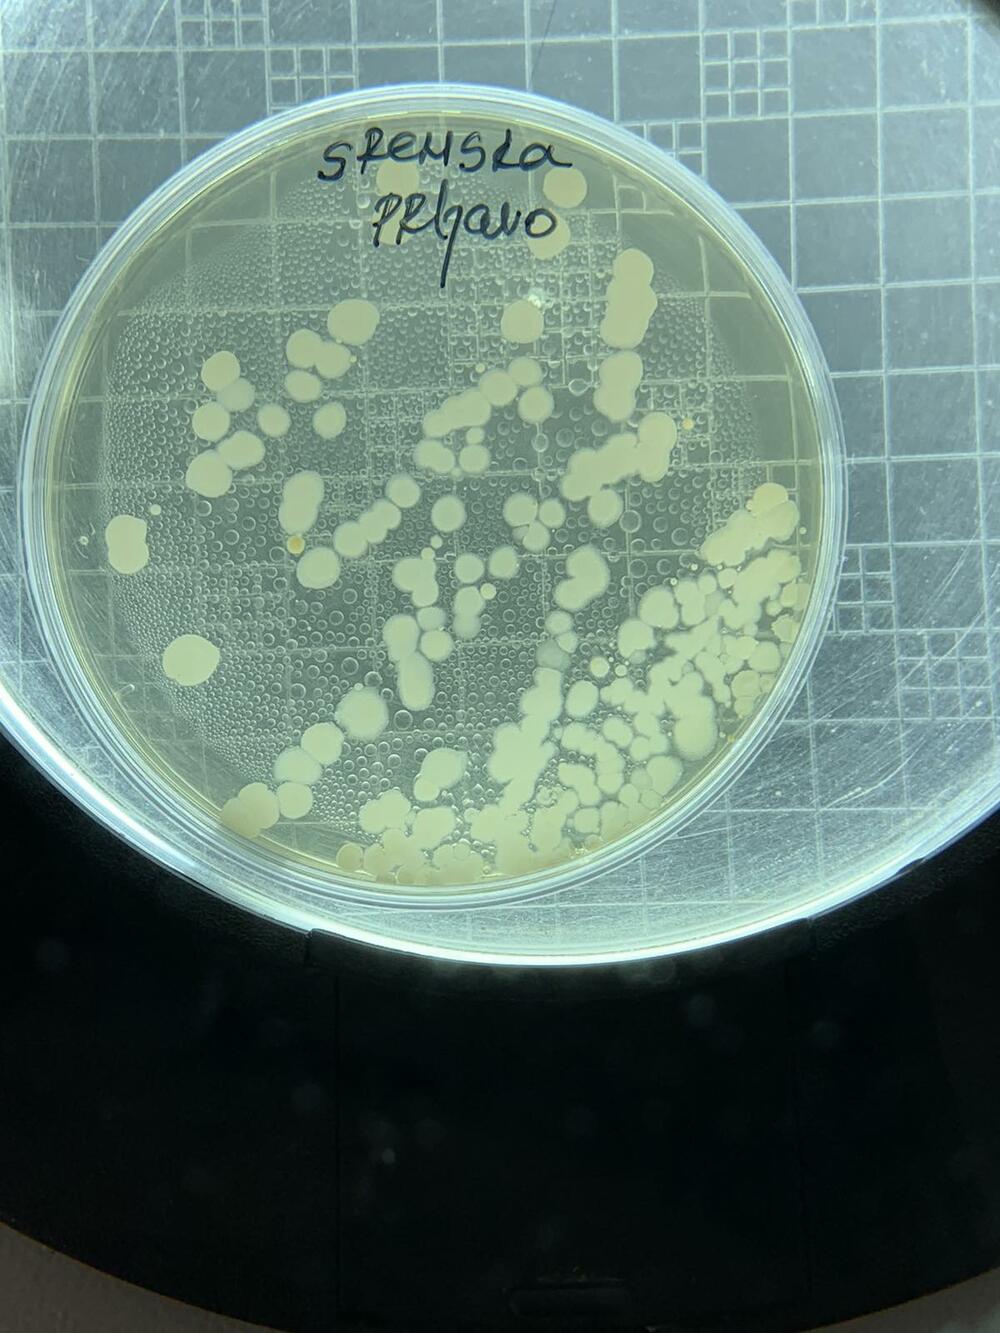
Sunđer
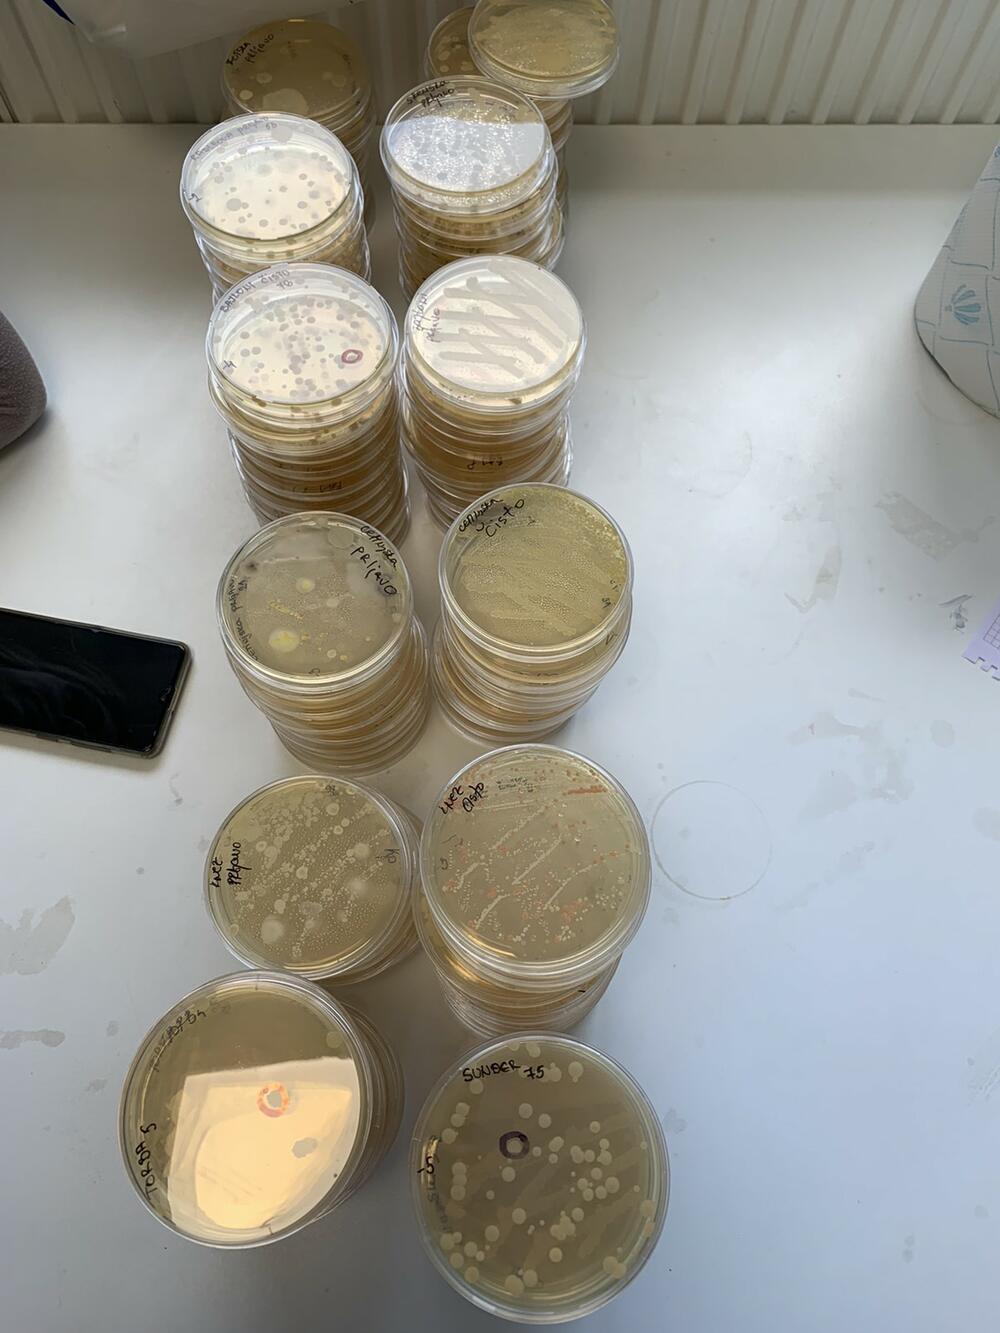
Sunđer
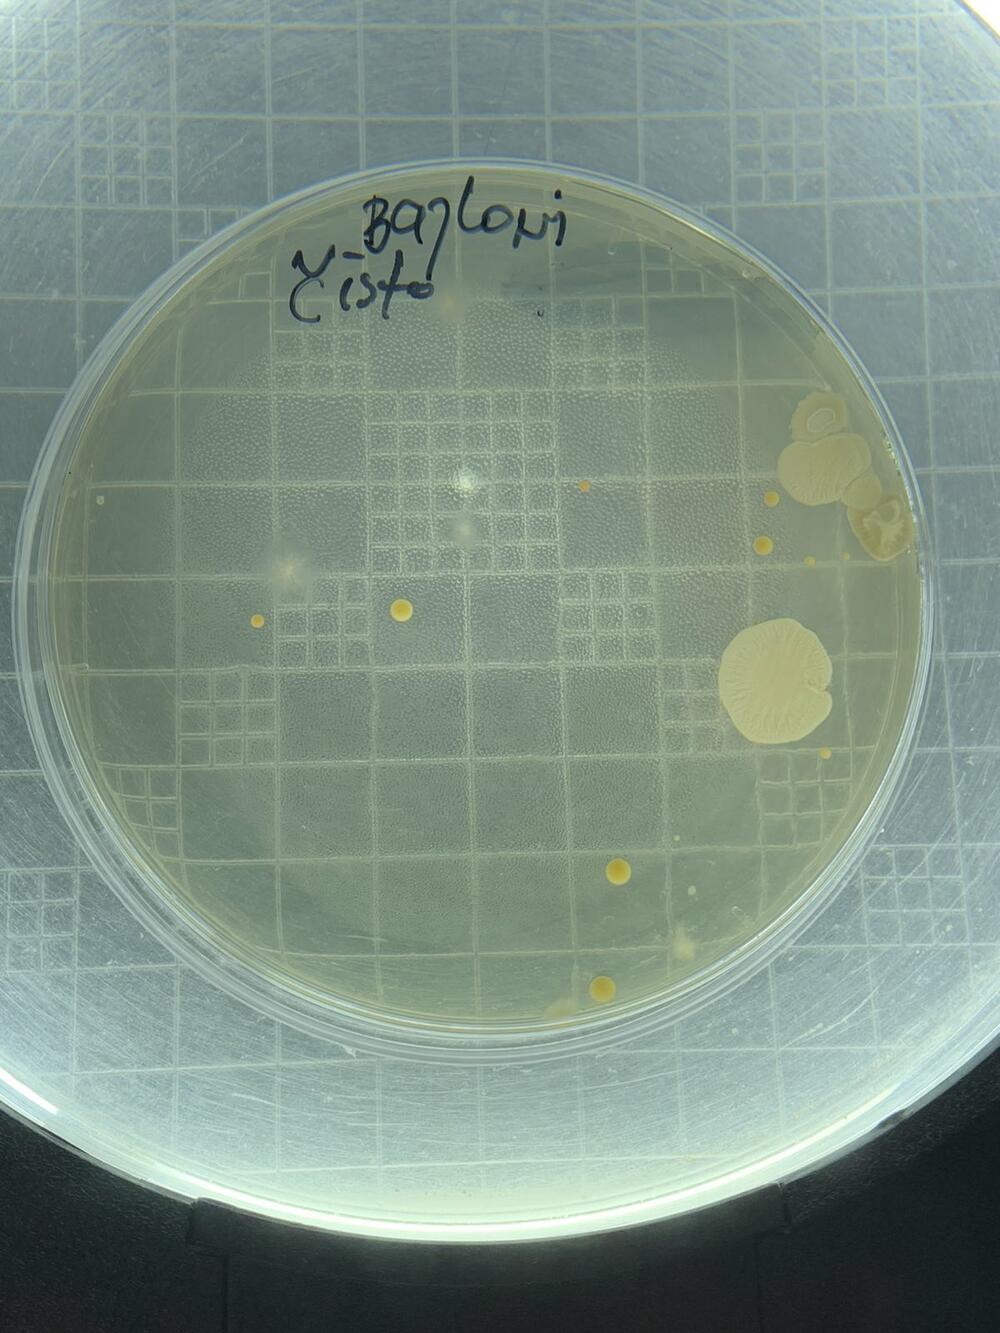
Sunđer

rezultati koji će vas iznenaditi
KUHINJSKI SUNĐER PRLJAVIJI OD KONTEJNERA: "Gradska čistoća" sprovela istraživanje, ovo je rezultat (FOTO)
Prosečna brojnost mikroorganizama na beogradskim kontejnerima iznosi 3,2x10 4 (32.000), a analizma su izolovani mikroorganizmi iz rodova bacillus-a, staphylococcus i streptococcus, kao i na kuhinjskom sunđeru i tašni, dok je razlika samo u njihovoj brojnosti
Istraživanje koje je sprovela laboratorija JKP „Gradska čistoća“ pokazuje da beogradski kontejneri, očekivano, nisu čisti, ali i da je kuhinjski sunđer koji se svakodnevno koristi u domaćinstvima pobednik u nadmetanju predmeta koji su najzagađeniji mikroorganizmima.
Tokom istraživanja zaposleni u laboratoriji JKP „Gradska čistoća“ analizirali su uzorke uzete sa 1.000 beogradskih kontejnera neposredno pre i posle pranja ovih sudova za odlaganje otpada. Dobijene nalaze uporedili su sa rezultatima analize uzorka kuhinjskog sunđera i brisa uzetog sa ženske tašne. Na jednom od 1.000 kontejnera zabeležena je brojnost kolonija mikrooganizama, veća nego na ostalim i to 4,5x10 7 (45 miliona), ali kuhinjski sunđer sa 7,5x10 7 (75 miliona) nijedan kontejner nije uspeo da nadmaši.
Dok nalaz brisa ženske tašne potvrđuje da je ovaj predmet čistiji od sunđera i neopranog kontejnera, ali broj kolonija zabeležen na njoj najpribližniji vrednostima zabeleženim na kontejnerima posle njihovog pranja vrućom vodom.
Tada je brojnost kolonija iznosila samo 2x10 2 (200). Drastičan pad brojnosti mikrooganizama posle pranja kontejnera samo vrućom vodom, bez deterdženta, govori o tome da će se akcijama pranja beogradskih sudova za otpad, pri čemu se inače koriste deterdženti, ali bez sapunice, podići nivo čistoće na mnogo viši, iako dokazano kontejneri nisu najprljaviji predmet sa kojim sugrađani svakodnevno dolaze u kontakt.
Prosečna brojnost mikroorganizama na beogradskim kontejnerima iznosi 3,2x10 4 (32.000), a analizma su izolovani mikroorganizmi iz rodova bacillus-a, staphylococcus i streptococcus, kao i na kuhinjskom sunđeru i tašni, dok je razlika samo u njihovoj brojnosti.
„Analizu zagađenosti kontejnera sproveli smo da bismo videli da li i koliku učinkovitost pranjem sudova ostvarujemo. Sigurno smo da sad imali priliku da čujemo da je kuhinjski sunđer leglo bakterija i gljivica, ali se nadam da ćemo ovim analizama uspeti da razbijemo strah kod sugrađana koji se plaše da će otvaranjem i zatvaranjem kontejnera značajno ugroziti zdravlje. Verujem da posle odlaganja smeća, ne samo u kontejner, već i u svom domu, operemo ruke, jer mi se čini da je ovo više psihološka stvar, ali i da posle otvaranja tašne često zaboravimo da to uradimo, a kao što je analiza pokazala, očigledno ima potrebe za time“, kaže direktor JKP „Gradska čistoća“, Marko Popadić.
On je objasnio da kontejneri u Beogradu često ostaju otvoreni i da je najčešći razlog za to upravo strah sugrađana, jer ne žele da ih zatvore čak i kada imaju sistem nožne papauče.
„Svakodnvno se naši zaposleni nalaze u problemu, jer ako zatvore kontejnere posle pražnjenja, imamo deo sugrađana koji negoduje jer ne žele da ih otvaraju uvereni da su kontejneri najprljavija stvar u Beogradu. S druge strane imamo deo sugrađana koji negoduje ako ih ostavimo otvorenim, jer se iz njih šire neprijatni mirisi ili životinje lutalice i ptice razvlače otpad oko kontejnera. Naravno da kontejneri, izuzev posle pranja, neće mirisati, jer se u njih odlaže smeće, ali kao što vidimo nisu naprljaviji, a akcijama pranja obezbedićemo da budu još čistiji. Zato posle analiza koje smo sproveli, apelujem na sugrađane da slobodno koriste poklopce kontejnera, da naravno posle odlaganja otpada operu ruke i da u tom slučaju sigurno neće ugroziti svoje zdravlje. Akcijama pranja, dok nam vremenske prilike to dozvole, nivo čistoće kontejnera održavaćemo na visokom nivou, a prostor oko kontejnera će biti znatno čistiji ukoliko ih posle upotrebe zatvaramo“, kaže Popadić i ističe da se najprljaviji kontejneri nalaze u blizini objekata koji prodaju prehrambene proizvode.
(Espreso)
Uz Espreso aplikaciju nijedna druga vam neće trebati. Instalirajte i proverite zašto!







